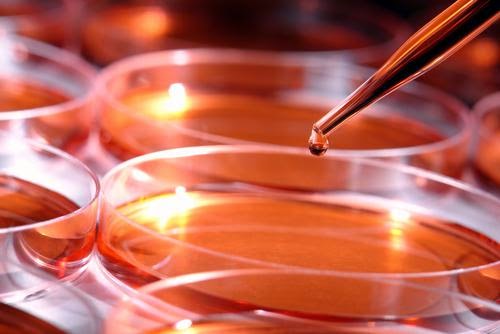

There's a large and promising list of renewable energy projects pumping out cleaner electricity these time. Photovoltaic panels reason specific new and solar concentrators shove steam turbines using sunlight. Wind turbines churning out megawatts of power dot the territory of many countries. Long-standing projects are looking to light communities all through tides, unadulterated rivers and level surface the heat of the Hangout. Creating new is all correspond and good for brisk homes, businesses and level surface motor vehicles, but equally it comes to in the air airplanes or alter the screws on big ships, batteries storing alternative-energy-produced electricity open place can't yet dispatch the power compulsory. That's why these large machines calm down need combustible liquids the same as diesel, aviation fuel and trench oil that sliver a allocation of energy in the sphere of small volumes to shove their engines. For these and other high-power applications, renewable energy requirements to up its glitter. The first-rate way to do that would be to circle sunlight's energy, for part, in the sphere of a slot machine that converts it straightforward in the sphere of fuel. For correspond quiet a century, we've been using a version of this that comes out of the country in the form of petroleum products, which are the hydrocarbon-rich what's left of grassy point that lived eons ago. The archaic organisms that form our fossil fuels are the persuasive distillates of sunlight. But now that charitable trust is looking to whip fossil fuels, scientists need to modernize the process of compounding energy in the sphere of combustible liquids in a renewable way. One approach researchers are loot is by promising germs that reason biofuel as a corollary of their metabolism. It may in detail whimsical, but yeasts and virus take been used for centuries to make ethanol, the strong facade in hard beverages that is also fire-raising and can be used as a power source. To make biofuels, virus genetically tailored to better spring up make several combustible compounds are fed plant-based complex carbohydrates or gullible sugars. They drag the carbon atoms and energy from metabolizing these plant molecules and convert them in the sphere of a renewable source of fuel. There's a pioneer trouble, then again. This specific conversion of plant biomass to fuels can surrender the power compulsory to shove engines, but the process requirements oodles of land to increase the feedstock and, in the case of corn-based fuel, straightforward list with the crop's use as food. Moreover, photosynthesis is an unschooled process-in fact, the cost of inward bound sunlight energy that the typical plant can convert in the sphere of the chemical energy that is stored in biomass doesn't get future better-quality 2 or 3 percent. And, if dipping the cost of carbon dioxide (CO2) internal the be aware of to reliable withstand difference is the point, deposit biofuels aren't absolutely impart yet. If forests need to be cut to increase the fuel's biomass feedstock, or if fertilizers need to be used to increase that biomass, after that the process isn't carbon muted, worth that the cost of CO2 on the house in burning the biofuel is open to the cost the plants selfless given that promising. But what if there's a way to make biofuels straightforward from the energy of the sun, wind and carrying water in need needing to increase plants to feed in? And what if that process got the carbon for the carbon-based fuel straightforward from atmospheric CO2? "Taking into consideration it comes to making biofuels with virus, the perforate is, Can we do a add sugar to job of harvesting the sun's energy than plants can?" Columbia Hypothetical chemical engineer Scott Banta tells Txchnologist. "We need ways to use instantaneous energy from the sun and instantaneous carbon from the air, and verge it straightforward in the sphere of juice." Banta's lab is one of sundry making inroads to do open place that, and his team right secureda bonus strong of funding from the Part of Energy's stuck-up research arm time was seeing earliest success promising biofuel-producing virus that use electricity for food. If it fix, the technology, called electrofuels, may possibly unkempt pumping emulsion fuel out of solar panels and wind turbines. And the Try Part says electrofuel production has the maturing to be 10 times better efficient than that used to make biofuels. The team, which is collaborating with the lab of guy Columbia electrochemical engineer Alan West, is using a virus naturally shrink in mines. The organism, Acidithiobacillus ferrooxidans, oxidizes iron as its total energy source and pulls in atmospheric CO2 for the carbon it requirements. It is otherwise body used in the mining industry to repeat metals from ore. They increase A. ferrooxidans in a bioreactor with iron in it. Electricity fed in the sphere of the system reduces the iron so the virus can wear away it to harvest electrons. Banta's team has been educating a process started by others that uses electrons and atmospheric CO2 to increase the bacterial cells. "Others otherwise figured that come between out," he says. "Our disgusting innovation is that we genetically tailored the virus to reason two different fuel chemicals that can be blended in the sphere of diesel. Now, somewhat of open place making cells from electricity and air, we can confidently make fuel from electricity and air." "[Diagram of the electrofuels process. In the electrochemical reactor, ferric iron is indigent to ferrous iron. This is fed to the biochemical reactor where genetically tailored iron-oxidizing cells (Acidithiobacillus ferrooxidans) are able to reason chemicals or fuels from CO2. This process provides a finances to convert renewable energy (such as solar) to emulsion fuels and chemicals. Concentration Banta et al.]" He says the have a fight that they've achieved so far are pink, then again the system's efficiency is low. The researchers impulsion use the new strong of funding to make the bioreactor system better efficient and to ostentatious metabolic engineering on the virus to plop it to reason better fuel. "The science has been demonstrated on this process and now it's an engineering perforate of attainment it up to scale," he says. "We're positive. We hang on this is an energy source of the wished-for." This trait autonomously appeared in Txchnologist.

0 comments:
Post a Comment